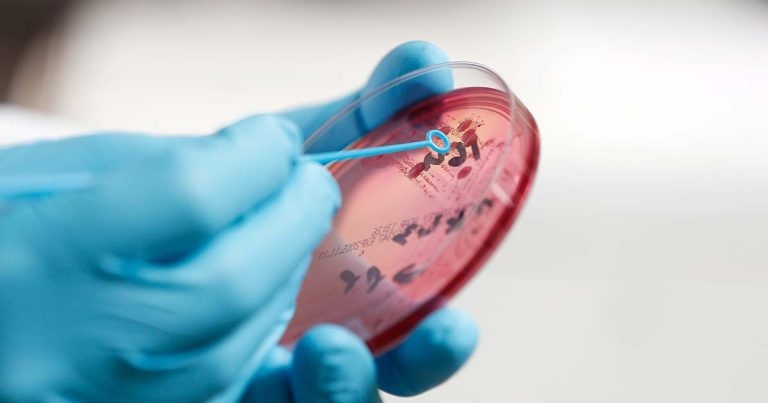
Diagnosing equine skin diseases

17 Apr 2017
David Rendle discusses finding the correct method of identifying the dermatological conditions that affect horses.
Figure 8. Bacterial culture is frequently overlooked in the investigation of equine skin disease.
Skin disease in horses is common, but presents a considerable challenge. Different diseases have similar clinical manifestations and definitive diagnoses may be elusive.

Histology of skin biopsies is arguably the most useful single diagnostic test, but is invasive and owners frequently expect to be given a diagnosis based on the appearance of the lesions alone. There is often pressure to treat empirically, but this can frustrate subsequent diagnostic investigation. The temptation to treat empirically with antimicrobials should be resisted unless bacterial culture or histology indicates a bacterial aetiology.
Skin scrapings are straightforward and are performed frequently in equine practice. However, they are often unrewarding. Samples are, by their nature, very superficial and comprise scale that will not enable diagnosis of many common equine skin conditions.
Deeper scrapes can be performed by pinching the skin between finger and thumb and using a scalpel blade to scrape the skin until capillary bleeding occurs. However, by contrast to small animal practice, few occasions exist when this is likely to add anything over superficial scrapings.

Superficial skin scrapings may be helpful in the diagnosis of dermatophytosis. Scrapings are best taken from the periphery of the lesions where the arthrospores are more likely to be visible microscopically (Figure 1). Placing the sample in 10% potassium hydroxide will destroy a lot of the debris, making it easier to identify fungal components. Scrapings from the distal limbs are useful in the identification of Chorioptes mites (Figure 2). Removal of superficial crusts for microscopy and bacterial culture enables diagnosis of dermatophilosis (rain scald).
Performing tape impressions is quicker and more straightforward than skin scrapings. The samples obtained are very superficial, but as few occasions exist where deeper skin scrapings are useful, tape impressions are often just as helpful. Acetate tape is applied with gentle pressure to collect material from the skin surface. The tape is then applied gently to a microscope slide without pressure and is viewed under the microscope.
Tape impressions are particularly useful and would be the test of choice for the identification of Oxyuris equi (pinworm) eggs from around the anus (Figures 3 and 4).

Acetate tape impressions are less effective in horses with long, greasy hair coats. These are, unfortunately, the horses commonly affected by Chorioptes mites, which the tape is often used to detect. Clipping can facilitate collection of tape impressions, but also results in some of the material being lost. The collection of brushings using a toothbrush is another means of collecting superficial scale, should mites be suspected.
In addition to detecting Chorioptes bovis, tape impressions can also be used for the collection and identification of less common ectoparasites that can cause skin disease of the distal limbs, such as Dermanyssus gallinae (poultry mites) and Trombiculidae (harvest mites), or the trunk, such as Damalinia equi or Haematopinus asini (lice; Figure 5).
Plucks of hair may be useful for identification of dermatophytes and for bacterial or fungal culture, if dermatophytosis or bacterial folliculitis is suspected.
Hair plucks are also helpful in the investigation of alopecia. Microscopic examination of the roots of hairs allows determination of the stage of their growth. A normal hair pluck should have hairs in both
If all the hairs present are in the same phase of growth, this may indicate telogen effluvium. Examination of hair shafts is also important. If all the hairs are damaged or fractured at a similar level, this may indicate anagen effluvium – a period of interrupted hair growth caused by a stressful event. Irregular damage or fracture of the hairs is likely to be due to self-trauma associated with pruritus.
Fine-needle aspirates are potentially useful for the diagnosis of nodular skin diseases. However, in contrast to small animals, many of the more common nodular diseases of horses, such as sarcoids, are difficult to aspirate and frequently fail to yield material that enables a diagnosis to be reached. Tru-cut tissue biopsies are only slightly more invasive and provide sections of tissue far more likely to provide a definitive diagnosis.

Where bacterial infection is suspected, it is appropriate that swabs or tissue samples are collected and submitted for bacterial culture (Figure 8). If swabs can be collected from pustules or discharging tracts without contamination from the skin surface then this is appropriate.
Aseptic preparation of skin surface prior to sampling deep lesions will reduce the risk of confounding results with contaminating or commensal bacteria from the skin surface. If there are pustules or lesions consistent with folliculitis then punch biopsies can be collected following aseptic preparation of the skin surface and macerated into a suitable media prior to bacterial culture.
Bacterial culture of superficial skin scrapes is rarely rewarding and more likely to yield growth of contaminants or commensals of no clinical relevance. Fungal culture or polymerase chain reaction of scrapes from scaling dermatoses may enable diagnosis of dermatophytosis.

Punch biopsies are arguably the most useful diagnostic test for superficial skin diseases, but it is the author’s impression they are not performed as often as they might be (Figure 9). They are often left until the horse has received various treatments, systemic and topical, which may compromise the value of histology; glucocorticoids, in particular, should be avoided prior to biopsy.
The cost of inappropriate empiric treatment will easily outweigh the cost of biopsy and subsequent histology, so biopsies should be considered early in the course of disease. Frequently variation exists in the histologic appearance of skin lesions, so it is important to collect at least three or four punches from different locations to obtain samples representative of the whole disease process. Samples should be taken from the centre, as well as the periphery, of large lesions. The larger the biopsy the better – an 8mm diameter biopsy bunch is ideal (Figures 10 and 11).
For nodular skin lesions, tru-cut biopsies are more appropriate than punch biopsies as they enable the centre of the lesion to be sampled (Figure 12). Various tru-cut biopsy needles and guns are available. Needles with a spring-loaded cutting device are superior as they will cut through fibrous masses where some manual cutting devices will fail. The larger the diameter of the core, the better.
The procedure is straightforward, the overlying skin is aseptically prepared and the nodule is fixed (generally between finger and thumb) while the biopsy device is fired with the other hand. Local anaesthetic can be placed under the skin. Consideration needs to be given to the length the needle will extend when fired to ensure deeper structures (and digits) are not inadvertently damaged.

In some scenarios, the nature of a skin nodule may be obvious or the decision to remove it may be made without the need for a definitive diagnosis. In this situation, it may be more practical to excise the mass and submit it for histology to confirm its nature and that adequate margins have been obtained (Figures 13 and 14).
While some research exists to support the use of serology to diagnose skin allergy, the weight of evidence and expert opinion indicates it is unreliable. The repeatability – both within and between methods – is extremely poor, and there is little agreement with the results of intradermal skin testing, which is regarded as the gold standard for diagnosing skin allergies.
Intradermal skin testing is a safe, straightforward technique that is useful in identifying the cause of atopic dermatitis (Figure 15). The technique should be considered in all horses exhibiting generalised pruritus that is likely to be allergic in aetiology.
The clinical signs of atopy may be indistinguishable from insect bite hypersensitivity, so if the latter cannot be diagnosed on historical features then intradermal skin testing should be considered.
mammalian epithelia – is injected into the skin and the reactions are monitored for up to 24 hours. All horses will react to these extracts to some extent and comparisons are made with a positive control (histamine), and a negative control (saline), to differentiate reactions, which are likely to be due to allergic responses from those likely to be purely inflammatory.
There is as much art as science in this process and the horse’s history has to be considered when determining which reactions are likely to be of clinical relevance and which extracts merit inclusion in allergen-specific immunotherapy.
Positive results to intradermal skin testing do not provide confirmation of atopy, merely an indication of likely allergens in a horse that is atopic. If the diagnosis of atopy is in doubt then punch biopsies should be performed to look for changes that are characteristic of allergy.
Investigation of equine dermatological disease can present challenges, but the relevant diagnostic techniques are relatively inexpensive and should be considered early in the disease course prior to lengthy courses of empiric, and potentially inappropriate, treatment.